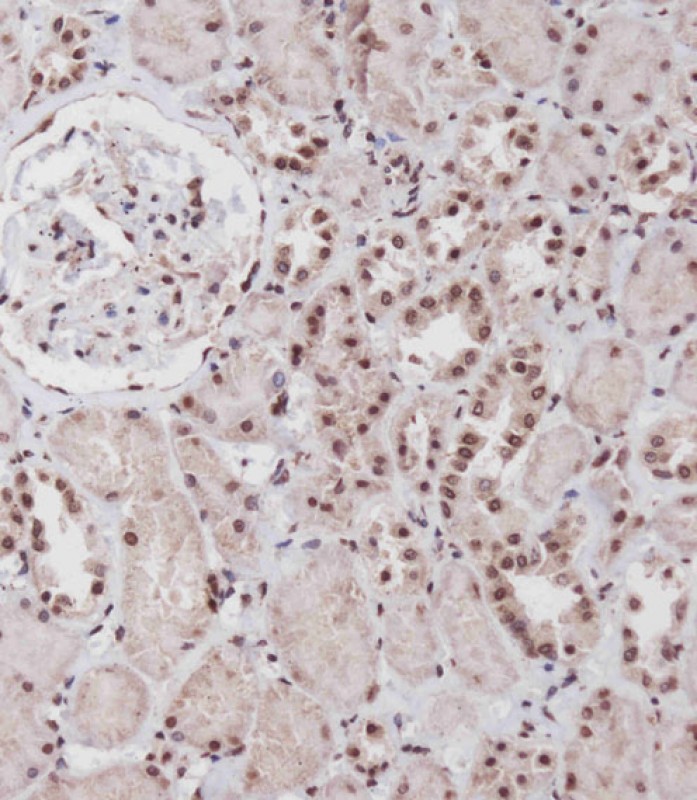

-
分类: 科研抗体货号: P34724别名: Male-specific lethal 1 homolog, MSL-1, Male-specific lethal 1-like 1, MSL1-like 1, Male-specific lethal-1 homolog 1, MSL1, MSL1L1应用: WB反应种属: Human, Mouse
-
分类: 科研抗体货号: P34704别名: Scavenger receptor class A member 5, Scavenger receptor hlg, SCARA5应用: WB,IHC反应种属: Human, Mouse
-
分类: 科研抗体货号: P34738别名: Calcitonin gene-related peptide 1, Alpha-type CGRP, Calcitonin gene-related peptide I, CGRP-I, CALCA, CALC1应用: WB反应种属: Human
-
分类: 科研抗体货号: P34723别名: Protocadherin-9, PCDH9应用: WB,IHC反应种属: Human
-
分类: 科研抗体货号: P34732别名: Integrin alpha-11, ITGA11应用: WB反应种属: Human, Mouse
-
分类: 科研抗体货号: P34737别名: WD repeat-containing protein 41, WDR41应用: WB,IHC反应种属: Human, Mouse
-
分类: 科研抗体货号: P34722别名: Single-minded homolog 1, Class E basic helix-loop-helix protein 14, bHLHe14, SIM1, BHLHE14应用: WB,IHC反应种属: Human, Mouse, Rat
-
分类: 科研抗体货号: P34731别名: Hemopexin, Beta-1B-glycoprotein, HPX应用: WB,IHC反应种属: Human, Mouse, Rat
-
分类: 科研抗体货号: P34736别名: Ankyrin repeat and SOCS box protein 17, ASB-17, ASB17应用: WB,IHC反应种属: Human, Mouse
-
分类: 科研抗体货号: P34720别名: Collagen alpha-2(VIII) chain, Endothelial collagen, COL8A2应用: WB,IHC反应种属: Human, Mouse, Rat

鄂公网安备42018502007531号
鄂公网安备42018502007531号

